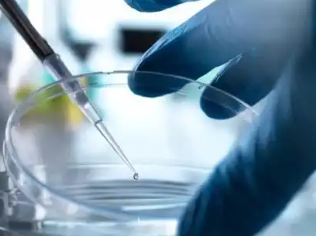

早泄一直是困擾眾多男性健康的醫(yī)學(xué)問題。傳統(tǒng)治療方法往往效果有限,近年來,干細(xì)胞注射逐漸成為一種新的治療選擇。那么,干細(xì)胞注射治療早泄的效果如何?有沒有可能產(chǎn)生副作用?本文將對(duì)此進(jìn)行深入探討。
什么是干細(xì)胞治療?
干細(xì)胞是未分化的細(xì)胞,具有自我更新和分化成多種細(xì)胞類型的能力。在醫(yī)學(xué)領(lǐng)域,干細(xì)胞治療被用來修復(fù)受損的組織和器官。對(duì)早泄的研究表明,干細(xì)胞可能通過促進(jìn)組織再生和修復(fù)來改善勃起功能和性能力。
干細(xì)胞注射治療早泄的機(jī)制
干細(xì)胞注射治療的機(jī)制主要包括以下幾個(gè)方面:
1.組織修復(fù):干細(xì)胞能夠向損傷部位遷移,并分化成相應(yīng)的細(xì)胞類型,促進(jìn)局部組織的修復(fù)。
2.增加血管生成:干細(xì)胞可以促進(jìn)血管新生,改善血流,從而增強(qiáng)勃起功能。
3.調(diào)節(jié)神經(jīng)功能:研究顯示,干細(xì)胞可能在神經(jīng)修復(fù)和再生中發(fā)揮重要作用,對(duì)早泄相關(guān)的神經(jīng)功能障礙具有改善作用。
臨床研究結(jié)果
近年來,對(duì)干細(xì)胞治療早泄的臨床研究逐漸增多。一些小規(guī)模的臨床試驗(yàn)結(jié)果表明,干細(xì)胞注射能顯著改善早泄癥狀,提高患者的性滿足感和生活質(zhì)量。
然而,這些研究大多處于早期階段,樣本量相對(duì)較小,缺乏長(zhǎng)期隨訪數(shù)據(jù)。因此,盡管初步結(jié)果令人鼓舞,但尚需更大規(guī)模的隨機(jī)對(duì)照試驗(yàn)來驗(yàn)證其長(zhǎng)期效果和安全性。
干細(xì)胞治療的副作用
盡管干細(xì)胞治療在一些領(lǐng)域顯示出良好的前景,但也存在潛在的副作用。這些副作用包括:
1.感染風(fēng)險(xiǎn):任何注射手術(shù)都存在感染的風(fēng)險(xiǎn),干細(xì)胞注射也不例外。
2.免疫反應(yīng):患者可能對(duì)注射的干細(xì)胞產(chǎn)生免疫反應(yīng),導(dǎo)致局部或全身性不適。
3.腫瘤風(fēng)險(xiǎn):雖然相關(guān)研究尚未證實(shí),但有理論認(rèn)為,異常增殖的干細(xì)胞可能帶來腫瘤形成的風(fēng)險(xiǎn)。
干細(xì)胞注射治療早泄在某些方面顯示出積極的效果,但仍需進(jìn)一步的研究來探討其長(zhǎng)期安全性和有效性。對(duì)于考慮這種治療的患者,建議在專業(yè)醫(yī)療機(jī)構(gòu)進(jìn)行詳細(xì)咨詢,并權(quán)衡可能的風(fēng)險(xiǎn)與收益。未來,隨著科學(xué)技術(shù)的不斷進(jìn)步,我們期待干細(xì)胞治療能夠?yàn)樵絹碓蕉嗟脑缧够颊邘砀R?。但在此之前,患者?yīng)謹(jǐn)慎選擇合適的治療方案,并確保治療過程的安全與科學(xué)。



